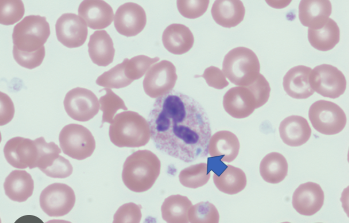
<ul><li><p>Light-blue stain in the cytoplasm of neutrophils</p></li><li><p>Condition: bacterial infections</p></li></ul><p></p>
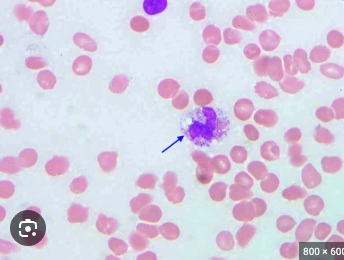
<ul><li><p>Visible vacuoles (clear holes/empty spaces) in the cytoplasm neutrophils </p></li></ul><p></p>
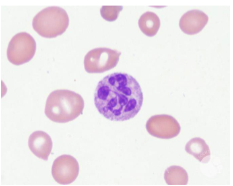
<ul><li><p>≥5 lobes of nuclei in neutrophils</p></li><li><p>Condition: megaloblastic anemia (B12 deficiency)</p></li></ul><p></p>
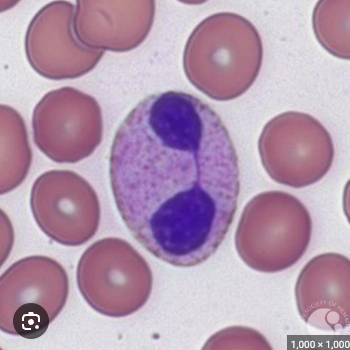
<ul><li><p>1to 2 lobed nuclei, failure of neutrophils to segment</p></li></ul><p></p>
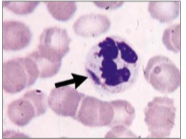
<p>Large granules in cytoplasm of neutrophils</p><p></p>
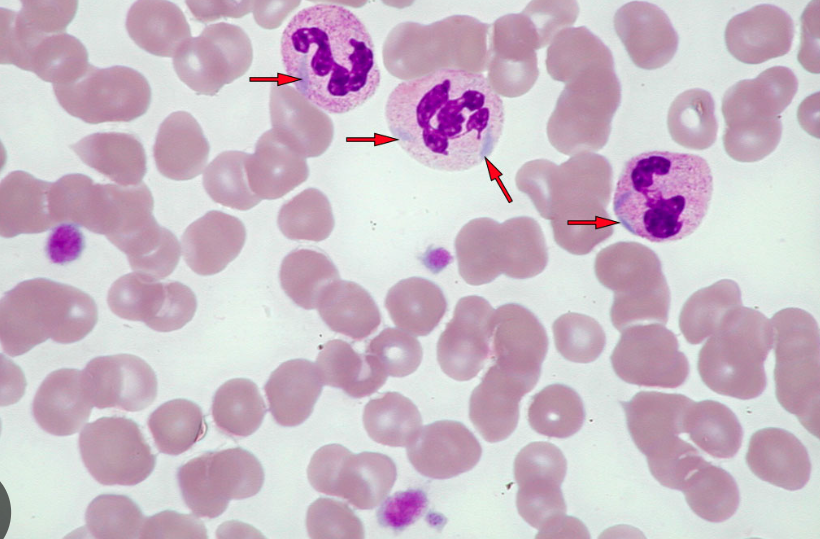
<p>Blue include bodies visible in neutrophils</p>
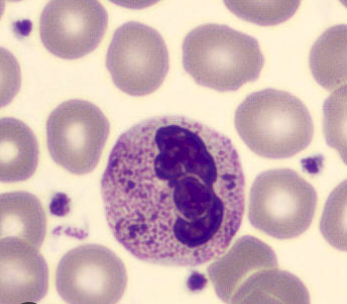
<p>Heavy, dark azurophilic granules</p>
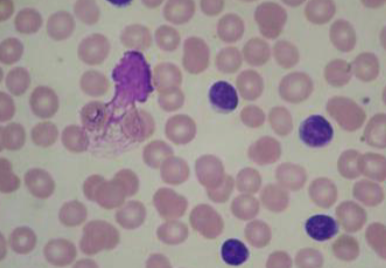
<p>Damaged white blood cells</p>

1/12
Looks like no tags are added yet.
Name | Mastery | Learn | Test | Matching | Spaced | Call with Kai |
|---|
No analytics yet
Send a link to your students to track their progress
Percentages & Appearances of WBC Types
Never Let Monkeys Eat Bananas
Neutrophil: 55-70%
A: segmented neutrophils
B: band neutrophils
C: Lymphocyte: 20-40%
D: Monocyte: 2-8%
E: Eosinophil: 1-4%
F: Basophil: 0.5-1%

WBC Functions
Neutrophils: first responders, phagocytosis of bacteria
Lymphocytes: immune response, B cells = antibodies, T cells = regulation, NK cells: eliminate infected cells
Monocytes: differentiate into macrophages, phagocytosis, antigen presentation
Eosinophils: kills parasites, allergic responses
Basophils: release histamine, inflammation response
Leukocytosis
WBC count above normal
Leukopenia
WBC count below normal
Toxic Granulation
Dark staining of prominent granules in cytoplasm of neutrophils
Conditions: bacterial infections

Dohle Bodies
Light-blue stain in the cytoplasm of neutrophils
Condition: bacterial infections
Toxic Vacuolization
Visible vacuoles (clear holes/empty spaces) in the cytoplasm neutrophils
Hyper Segmentation
≥5 lobes of nuclei in neutrophils
Condition: megaloblastic anemia (B12 deficiency)
Pelger-Huet Anomaly
1to 2 lobed nuclei, failure of neutrophils to segment
Chediak-Higashi Anomaly
Large granules in cytoplasm of neutrophils
May-Hegglin Anomaly
Blue include bodies visible in neutrophils
Alder-Reilly Anomaly
Heavy, dark azurophilic granules
Smudge Cells
Damaged white blood cells